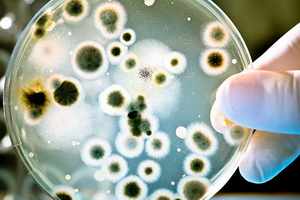

В Воронеже
В четверг, 11 июня, региональный оперативный штаб сообщил о 239 подтверждённых случаях Covid-19 за последние сутки. Это второй результат с начала пандемии после вчерашнего рекорда (242).
Гидрометцентр России объявил в Воронежской и соседних областях оранжевый уровень погодной опасности в связи с аномальной жарой. Она будет только усиливаться. Апофегей наступит 12 июня, когда воздух в Воронеже может прогреться до плюс 36°С, что существенно выше максимума этого дня.
Утром 10 июня региональный оперативный штаб сообщил о 242 подтверждённых случаях Covid-19 за последние 24 часа. Всего за время пандемии в Воронежской области было выявлено 3527 случаев. Выздоровели 1817 человек, умерли 19.
Проектный институт «Гипрокоммундортранс» представил архитектурные концепции по реконструкции Воронежского государственного театра оперы и балета. Решения не окончательные, а обсуждаемые.
Управление Роспотребнадзора по Воронежской области в третьей декаде мая текущего года проведело отбор 196 проб воды из открытых водоёмов на соответствие требованиям гигиенических нормативов по санитарно-химическим, микробиологическим, паразитологическим, вирусологическим показателям.
9 июня региональный оперативный штаб проинформировал о 220 новых случаях Covid-19. Всего за время пандемии в регионе инфицировано 3285 человек. Выздоровели 1699, умерли 19 человек.
Утро без телевизора напрягло воронежцев
В понедельник многие воронежцы, привыкшие начинать утро с телевизора, почувствовали дискомфорт, увидев на всех каналах пустоту. Да, об отключениях телевещания предупреждали заранее, но всё равно без утренней порции информации некоторые граждане испытали ломку.
Региональный оперативный штаб сообщил в понедельник о 228 новых случаях заражения коронавирусом. Это новый впечатляющий рекорд. Всего за время пандемии в регионе инфицировано 3065 человек. Выздоровели 1692 человека. Умерли – 19.
Утром в воскресенье региональный оперативный штаб сообщил о 139 новых случаях заражения SARS-CoV-2 в Воронежской области. Всего, таким образом, в регионе инфицировано 2837 человек, побороли болезнь за всё время эпидемии 1692 пациента. Умерли – 19.
За сутки инфекция поразила в Воронежской области ещё 106 человек, и один пациент скончался. Вечером в пятницу региональный оперативный штаб сообщил, что число жертв коронавируса в регионе достигло 19. По этому показателю область занимает в стране 34-е место.